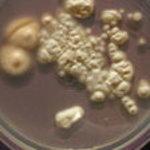
keime.jpg

Bioabfallverwertung

Mit der getrennten Bioabfallerfassung und -verwertung lassen sich organische Abfälle in hochwertige Komposte für Landwirtschaft, Landschafts- und Gartenbau überführen und sind damit ein gutes Beispiel für die stoffliche Kreislauführung. Darüber hinaus leistet die Bioabfallverwertung einen wichtigen Beitrag für den Klima- und Ressourcenschutz.
Themen

Das Land Hessen strebt unabhängig von Bebauungsstrukturen und örtlichen Rahmenbedingungen den im Kreislaufwirtschaftsgesetzt verankerten Anschluss aller Haushalte an die Biotonne an. Häufig ist aber insbesondere im verdichteten Geschosswohnungsbau die Getrennterfassung von Wertstoffen durch geringe Bioabfallmengen und hohe Fremdstoffeinträge gekennzeichnet. Andererseits ist eine hohe Produktqualität der Komposte für eine nachhaltige Kreislaufwirtschaft der Bioabfälle unumgänglich. Eine Intensivierung der separaten Erfassung von organischen Abfällen in diesen Strukturen stellt somit eine große Herausforderung für die handelnden Akteure dar. Vor diesem Hintergrund wurden in einem Pilotprojekt Potentiale und Möglichkeiten zur Verbesserung der Qualität der erfassten Bioabfälle und insbesondere zur Reduzierung des Kunststoffanteils in der Biotonne im Bereich von Großwohnanlagen untersucht.

Die Bioabfallkompostierung ist ein bewährtes und etabliertes Verfahren zur Verwertung der organischen Abfälle. Als Beitrag zur nachhaltigen Entwicklung werden z.Z. Maßnahmen zur Effizienzsteigerung der Bioabfallverwertung weiterentwickelt. Dies beinhaltet auch die künftig stärkere Nutzung des energetischen Potentials des Bioabfalls in Hessen.
Das Witzenhausen-Institut für Abfall, Umwelt und Energie GmbH hat in einer vom Hessischen Ministerium für Umwelt, ländlicher Raum und Verbraucherschutz finanzierten Studie eine Potentialerhebung organischer Abfälle in Hessen durchgeführt und Möglichkeiten zur Optimierung dargestellt.